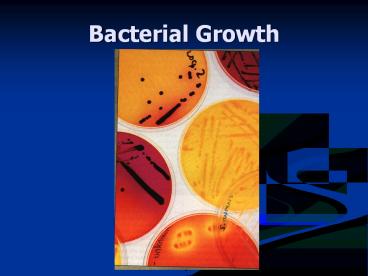

Bacterial Growth PowerPoint PPT Presentation
Title: Bacterial Growth
1
Bacterial Growth
2
- I. Determine in terms of population size.
- Nature there is a of organisms
living together. - How can we get a certain type of bacteria?
- - separating the progeny of a
single bacterium from all others.
3
- - interested in disease
causing bacteria (major contributor to pure
culture techniques). - Initially grew bacteria on potato surface but
had problem - Not enough for bacterial
growth. - Added gelatin as a solidifying agent. (Warm -
pour, cool - solid) - -
simplest most common method to isolate a
single bacterium. - Hesse (Kochs assistant)
(polysaccharide extract from marine algae) -
easier to work with then gelatin (solid over a
wider range then gelatin). - Julius Petri -
4
Streak-Plate Method
5
- II. Bacterial growth
- formula to determine population size
- b B2n
- Number of cells at time zero (beginning).
- number a cells at any later time.
- number of cell generations.
6
Review
- Why is agar used instead of gelatin or potato?
- Why is the petri dish unique to prevent
contamination? - What is the advantage of bacterial growing by
binary fission? What is the disadvantage? - How many bacteria will there be after 10 hours if
the bacteria double every 30 m inutes?
7
- A. Growth can be measured as an increase in
(weight) of the population. - B. Growth can be measured as an increase in
. - 1. - count the
number of colonies on the medium. - 2.
- counting the number of
bacterium in an known volume of liquid.
8
- III. Factors that influence microbial growth.
- A. Temperature
- 1. Most bacteria grow within or near
. - 2. groups of bacteria based
upon their optimum growth temperatures. - a. 5C - 20C
- b. 20C - 50C
- c. 50C - 80C
- d. 80C
9
Review
- Describe the difference between direct count and
plate count method. - What are the three temperate ranges that
bacteria tend live in?
10
- 3. Food Preservation
- Refrigerators food spoilage
because most of the microorganism that cause
spoilage are . - 4. Temperature Human diseases.
- Human body
- 37C (
). - 20C - 25C (
). - Ex - leprosy (Mycobacterium leprae)-
involves the regions of the
body.
11
(No Transcript)
12
Review
- Why do we store our food in refrigerators?
- Why do you not want to keep heating and cooling
the same leftover throughout the week? - Which temperature range to most tend to live in
and why?
13
- B. Oxygen Requirements
- 1. -
require free oxygen to grow. - 2. - will
not grow in the presence of free oxygen, may even
be killed. - 3.
-prefers the presence of low oxygen (2 - 10
Oxygen). - 4.
- lives in the presence of
both - Growth occurs more rapidly in the presence of
oxygen. - 5.
- will grow in the presence of oxygen but do
not posse an oxidative metabolism - Derive no benefit from the presence of oxygen.
14
- Why can some bacteria thrive in the presence of
oxygen but others are killed by it? - Oxygen can be converted into a toxic form like
(H2O2)
(O2-). - Cells that do not die in the presence of oxygen
produce enzymes ( ) into a form (H20
O2).
15
- C. pH
- Most bacteria grow best in an medium with a pH
of (neutral). - Can live in a wider range
- Ex. Helicobacter pylori - live in very
environments ( )
may cause ulcers. - Bacteria produce metabolic products that may
acidic or basic. - Need a ( ) to
grow bacteria.
16
- 4. - pressure that is
required to prevent the net flow of water across
the cell membrane. - effect
water movement. - Use salt as an factor
in food preservation.
17
- IV Cell multiplication requires a source of
energy raw material for synthesis of cell
components. - A. Bacterial Nutrients
- Raw Materials
- Carbon, Nitrogen, Oxygen, Hydrogen.
- all other compounds including ions.
- Two Purposes of nutrition
- 1. (Synthesize) protoplasm.
- 2. Supply energy to .
18
- B.
- C.
- D.
- Small organic molecules other than carbon that
bacteria must provide in order to grow (amino
acids vitamins).
19
V. Dynamics of population growth.